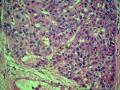

| 图片: | |
|---|---|
| 名称: | |
| 描述: | |
- 甲状腺肿物一例
| 性别 | 男 | 年龄 | 44 | 临床诊断 | 结节性甲状腺肿 |
|---|---|---|---|---|---|
| 一般病史 | 于14年前患者无意中发现右颈前一肿块,未伴疼痛、畏寒发热、吞咽梗阻等不适,无脾气性格改变,食量、体力正常,因无特殊不适,患者未进行处理。之后肿物稍增大,自感身体易疲劳。发病以来,精神、饮食、睡眠可,二便正常。入院查体:右颈前可见一肿块隆起,表面无红肿渗出,无触痛,约5.0cm*6.0cm大小,质韧,边界欠清,可随吞咽活动;未闻及明显血管杂音。双眼不突,双手细颤征阴性。 | ||||
| 标本名称 | 右侧甲状腺肿物 | ||||
| 大体所见 | 请参见大体照片 | ||||
标签:甲状腺肿物
-
本帖最后由 bobol 于 2014-11-07 17:06:26 编辑
×参考诊断